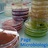

Your new post is loading...
 Your new post is loading...

|
Scooped by
Damien Steiner
December 7, 2021 4:44 PM
|
[Info] Concernant cette page
Cette page comporte 683 scoop publiés entre le 01/10/2011 et le 02/05/2015.
L'utilité de cette page a d'abord et avant tout été de centraliser et de faciliter la recherche d'articles publiés sur la page facebook du même nom : https://www.facebook.com/Microbiologie
Cette page n'est plus alimenté depuis de nombreuses années mais peut encore servir à certain(e)s, elle restera donc en archive. Bien cordialement, Damien Steiner

|
Scooped by
Damien Steiner
March 4, 2015 1:40 PM
|
Pour la première fois, des chercheurs français ont démontré l'implication d'un virus dans une stratégie de manipulation parasitaire.

|
Scooped by
Damien Steiner
January 20, 2015 4:11 PM
|
Une molécule naturelle découverte par une équipe américano-allemande s’est montrée efficace contre des bactéries responsables d’infections graves, comme la tuberculose.

|
Scooped by
Damien Steiner
November 5, 2014 1:33 PM
|
"Une équipe française a élucidé le mécanisme par lequel deux hommes, tous deux porteurs du virus de l’immunodéficience humaine (VIH), contrôlent spontanément l’infection. Celle-ci ne se manifeste par aucun signe clinique et le matériel génétique du virus n’est pas retrouvé dans leur sang. En fait, des séquences génétiques du VIH se sont insérées dans l’ADN des deux patients. Cependant, elles ne sont pas exprimées, probablement du fait de la stimulation d’un groupe d’enzymes habituellement inactivées par le virus."

|
Scooped by
Damien Steiner
October 31, 2014 7:43 AM
|
Bien que les études phylogénétiques indiquent que l’arsenic a été utilisé par les micro-organismes il y a plus 3,4 milliards d’années (Ga), aucun indice lié au cycle biologique de l’arsenic n’avait ét

|
Scooped by
Damien Steiner
October 22, 2014 6:43 AM
|
"Elles ont contracté le virus en plein Montpellier. Quatre personnes "qui ne rentraient pas de voyage" ont été contaminées par le virus du chikungunya "suite à des piqûres de moustiques"

|
Scooped by
Damien Steiner
October 22, 2014 6:35 AM
|
Les porteurs du VIH auraient entre 62% et 85% moins de risque de souffrir de sclérose en plaques par rapport à la population générale.

|
Scooped by
Damien Steiner
October 22, 2014 6:20 AM
|
Un probiotique contre l'obésité à l'horizon. C’est l’objectif de ces chercheurs de la Vanderbilt University qui viennent de modifier une bactérie E coli de manière à l’inciter à produire, une fois dans l’intestin, un composé thérapeutique qui inhibe le gain de poids, la résistance à l'insuline et quelques autres effets néfastes d'une alimentation trop riche en graisses. Les résultat

|
Scooped by
Damien Steiner
October 22, 2014 5:39 AM
|
Cette étude, publiée dans la revue Cell Host & Microbe, révèle comment les bactéries résistantes aux antibiotiques se regroupent en gangs pour partager les ressources nécessaires à l'infection chronique.

|
Scooped by
Damien Steiner
October 20, 2014 7:43 PM
|
Une campagne de promotion de la circoncision, pour réduire la contamination par le virus du sida, bénéficie également aux femmes, dont le risque...

|
Scooped by
Damien Steiner
October 20, 2014 6:46 PM
|
"[...] Les morilles Morchella crassipes prennent soin de leur cheptel : grâce aux réseaux des filaments fongiques, les champignons permettent aux bactéries Pseudomonas putida de se disperser et de proliférer. Les morilles alimentent leurs microorganismes, les collectent et en gèrent le stock en fonction de leurs besoins [...]"

|
Scooped by
Damien Steiner
August 1, 2014 6:39 AM
|
Le bilan de l'épidémie de fièvre hémorragique en grande partie due au virus Ebola en Afrique de l'Ouest ne cesse de s'aggraver avec plus de 1300 cas et 729 morts au 27 juillet, dont 57 en 4 jours, a indiqué jeudi 31 juillet l'OMS. "Entre les 24 et 27 juillet, un total de 122 nouveaux cas (confirmés, probables et suspects) ainsi que 57 décès ont été notifiés en Guinée, au Liberia, au Nigeria et en Sierra Leone", a précisé l'OMS dans un communiqué. Ces chiffres font apparaître une augmentation en 4 jours de 8,5% du nombre des décès et de 10,1% du nombre des cas depuis le précédent bilan de l'OMS. "La tendance (...) reste incertaine" alors que l'épidémie continue de se propager au sein des communautés et touche aussi désormais les soignants, avertit l'OMS.

|
Scooped by
Damien Steiner
August 1, 2014 6:25 AM
|
Stress, bactéries et accident vasculaire cérébral (AVC) sont liés selon des chercheurs de l'université d'Etat de New York.
|

|
Scooped by
Damien Steiner
May 2, 2015 2:23 PM
|
Non ! La tuberculose ne nous est pas venue du bétail : des analyses récentes démontrent qu’elle infectait nos ancêtres bien avant qu’ils ne découvrent l’élevage.

|
Scooped by
Damien Steiner
February 18, 2015 12:01 PM
|
Des chercheurs américains ont recensé l'ensemble des bactéries présentes dans le métro new-yorkais pendant 18 mois. Ce qui leur a permis de réaliser une cartographie précise.

|
Scooped by
Damien Steiner
November 12, 2014 10:28 AM
|
Le moustique tigre a frappé. Arrivé en France en 2004 et insidieusement installé dans dix-huit départements depuis, le petit Aedes albopictus est un nuisible du quotidien et une menace sanitaire en suspens.Voilà qu'il sème un nouveau cas de dengue "autochtone", signalé jeudi dans le Var. Ce n'est pas forcément le début d'une épidémie : trois victimes de cette "grippe tropicale" transmise par le moustique tigre avaient déjà été répertoriées. En 2010 à Nice et en 2013 près de Aix-en-Provence. Autr...

|
Scooped by
Damien Steiner
November 4, 2014 1:16 PM
|
"Un mécanisme de défense contre les bactéries a été identifié chez le planaire, un ver plat aquatique, ouvrant la voie à de nouveaux traitements contre la tuberculose. [...] Le planaire était essentiellement connu pour ses extraordinaires capacités de régénération : un planaire coupé en 279 fragments se régénère, en 15 jours, pour donner 279 vers ! Ce qui en fait un être potentiellement immortel, puisqu'il ne peut pas mourir de vieillesse. Les chercheurs français ont aussi découvert qu'il est capable de résister à des bactéries très pathogènes, voire mortelles pour l'Homme. Et ce grâce à 18 gènes."

|
Scooped by
Damien Steiner
October 22, 2014 6:49 AM
|
"Une nouvelle technologie par ultrason améliore les capacités de nettoyage de l'eau. Le StarStream, inventé et breveté par l'Université de Southampton, a été gratifié par le prix du Produit de l'année S-Lab qui récompense les innovations durables nées en laboratoire.
Le dispositif Starstream fait passer un courant d'eau à travers une buse qui génère des ultrasons qui entrainent la formation de bulles, améliorant ainsi la capacité de nettoyage de l'eau. Selon les chercheurs l'utilisation d'eau froide à la place d'eau chauffée permet d'économiser près de 80% d'énergie par rapport aux produits similaires et autant puisque l'appareil recueille et recycle l'eau utilisée. Il fonctionne également sans détergent limitant ainsi l'impact écologique du nettoyage."

|
Scooped by
Damien Steiner
October 22, 2014 6:38 AM
|
"Une nouvelle étude montre l'incroyable diversité des micro-organismes capables de survivre dans les eaux sombres et glacées.
Situé à 800 mètres sous la glace de l'Antarctique, plongé dans le noir et le froid, le lac Whillans est resté isolé de la surface pendant des milliers d'années. Des chercheurs viennent pourtant d'identifier près de 4.000 espèces de microbes dans ses eaux à 0°C."

|
Scooped by
Damien Steiner
October 22, 2014 6:23 AM
|
"Bactéries électroactives sur l'électrode de graphite d'une biopile Et si l’électricité prenait désormais sa source dans la nature grâce aux biopiles… Depuis dix ans, glucose, bactéries ou plantes inspirent les chercheurs à la quête d’une source d’énergie alternative et propre. Les biopiles fonctionnent comme des piles classiques à combustibles : elles transforment l’énergie chimique en énergie électrique. Seulement, à l’inverse de la pile chimique, qui n’est pas biodégradable, les composants de la biopile sont 100 % naturels. Au revoir donc manganèse et platine… des métaux lourds, rares et polluants. « Les piles classiques utilisent du platine, qui est un élément rare. Il serait par exemple impossible d’imaginer alimenter le parc automobile électrique avec ces piles, car on n’aurait pas assez de platine sur Terre. », explique Élisabeth Lojou, directrice de recherche qui développe des biopiles depuis maintenant trois ans."

|
Scooped by
Damien Steiner
October 22, 2014 6:17 AM
|

|
Scooped by
Damien Steiner
October 20, 2014 7:59 PM
|
Carcasses ramassées par terre ou rincées à l'eau sale, machines vétustes, contamination par la bactérie campylobacter... The Guardian dévoile la face cachée des plus gros abattoirs de poulet du Royaume-Uni.

|
Scooped by
Damien Steiner
October 20, 2014 7:37 PM
|
Titre : Nano Burgers with lettuce Grossissement : 3 000X Chaque année se tiennent plusieurs concours destinés aux photos prises avec des microscopes électroniques, comme le MNE ( Micro Nano Engineering ), l’EIPBN ( Electron, Ion, Photon Beam Technology and Nanofabrication ) ou encore le concours Français de l’Anadef . Je vous ai préparé une …

|
Scooped by
Damien Steiner
October 3, 2014 5:06 PM
|
Des chercheurs viennent de reconstituer le cheminement du virus du Sida, responsable de 75 millions d'infections et de 36 millions de décès dans le monde.

|
Scooped by
Damien Steiner
August 1, 2014 6:29 AM
|
Il pèse entre un et cinq kilos, vit dans vos intestins et se nourrit de ce que vous avalez. Mais loin de vous être hostile, le microbiote est votre indispensable allié.
|



 Your new post is loading...
Your new post is loading...